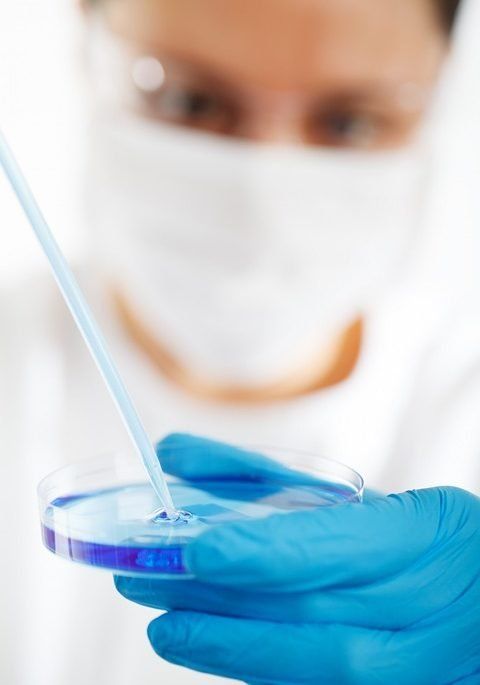

Statistics show that 5% of the world's population suffers from infertility. But modern medicine has found ways to overcome fertility problems. One of the most effective methods is in vitro fertilization or IVF for short. Many couples are turning to this cutting-edge technology in the hope of becoming parents, and Ufa residents are no exception. When it comes to choosing the right medical organization where this complex procedure can be carried out, then it is necessary to make a choice based on hard facts, and not advertising slogans.
Before proceeding directly to the rating of clinics in Ufa, you need to figure out, firstly, what the in vitro fertilization technique is, and secondly, how to choose the right place, because the health of the mother and the life of the unborn child are at stake.

IVF is one of the methods of artificial insemination. The essence of this method is that the fertilization of an egg is carried out not in the mother's body, but in the laboratory, or in a test tube, as they say. For comparison, artificial insemination by insemination is carried out intrauterinely, that is, in the patient's body, with the sperm of the husband or donor.
The decision on the need for IVF can only be made by a special doctor - a reproductologist, who will conduct a number of examinations of patients beforehand, as well as a course of treatment for infertility, which includes stimulation of ovulation and sometimes even surgery. Only after more gentle methods do not help, the doctor gives a referral for in vitro fertilization. But everything is not so simple, because in order to remove and fertilize an egg, it is necessary to perform a number of rather complex procedures.
In general, the entire IVF cycle can be divided into the following stages:


In cases where in vitro fertilization cannot be carried out due to severe health problems, couples turn to the services of a surrogate mother. Many hospitals offer services under this program, and parents-to-be can choose a suitable candidate, keep in touch with the surrogate mother throughout the pregnancy, and also use the help of lawyers to protect themselves after the birth of the child.
Having figured out the intricacies of IVF, you can start choosing a clinic in which you can carry out this difficult operation. It is necessary to evaluate a medical institution according to the following parameters: a list of services and research, the qualifications of doctors, the availability of equipment, the cost of services, as well as positive reviews and statistics. Availability of information on these points will help to avoid mistakes when choosing an organization. Selection criteria such as the mode of operation, location and interior of the hospital are secondary. Let's take a closer look at each of these points.
Since the IVF technique requires a thorough examination of future parents, an important factor in choosing a medical organization is, firstly, the availability of a full range of clinical and diagnostic studies before deciding on in vitro fertilization, and secondly, the ability to carry out all the manipulations in one place. Doubt is caused by medical centers, where couples are immediately offered to turn to this method without proper reason.
It must be remembered that this method is auxiliary, and competent specialists offer it only in case of unsuccessful use of the other, more sparing health options. Before that, doctors must carry out diagnostic and treatment studies of patients' health. After all, IVF has several alternative variations, which were mentioned above (ICSI, PIXI). And it is the doctor who selects the desired option.

For the successful preparation and implementation of IVF, it is recommended to contact reproductive doctors, and not to ordinary gynecologists. The result of treatment largely depends on this. Sometimes women visit a gynecologist for years, hoping for a miracle, lose precious time, and yet each of these specialists is focused on a certain range of health problems. Therefore, it is important to clarify whether the medical organization has reproductologists, and to make an appointment with this particular doctor.
It also does not hurt to clarify what work experience and academic degree this specialist has. And the most important recommendation is positive results. After all, a diploma and scientific works do not guarantee success. And it is also necessary to remember that doctors can change jobs by moving to another clinic. And if the doctor is a luminary in his field, wherever he works, the results of his patients will be high.

As it became clear from the description of the procedure, its implementation requires the use of first-class medical equipment.Sex cells are removed from the body, outside of which they are unable to exist. Therefore, laboratories must have high-quality storage equipment. A supportive environment must be created in which fertilization is likely to occur. In professional organizations there are separate rooms for all these manipulations.
Since the IVF method requires the use of a large amount of expensive resources, then we are not talking about its cheapness. On the contrary, potential parents should be confused by inexpensive services. This means that substandard drugs and equipment can be used for the procedure, which can cause irreparable damage to the mother's health and an unsuccessful result. It is not worth saving in this matter.
However, it is necessary to pay attention to the list of services provided, how much each of them costs, and whether they contain unnecessary or imposed analyzes to increase the cost. If you have doubts about the advisability of a particular study, then you need to ask the doctor a question and ask him to explain. Also pay attention to the value for money. In this question, focus on such a concept as the average price. It can be found out by analyzing all offers in the region. Of course, among the IVF options there are also budget programs that are aimed at families with low incomes.
The presence of a positive result is the main criterion in assessing a particular clinic. After all, it is for this that desperate couples come. The websites of many medical institutions contain patient reviews, but you need to read them carefully, because they can be written on request. Specialized forums where women who have already gone through this share their experience will be of considerable benefit. You can get in touch with them and ask questions about a particular clinic or specialist. In the process of communication, it will immediately become clear whether such a review is advertising or real.
And now, having understood the criteria for evaluating medical organizations, you can go directly to their rating. In Ufa, in vitro fertilization services are offered by four medical institutions. The choice is small, but the more carefully you need to approach the selection process. The advantages and disadvantages of each medical institution were evaluated based on the criteria listed above.
As the name of the medical center suggests, it specializes in problems related to childbirth. The medical institution operates on the basis of the hospital of the same name. As for the list of services and research provided, here patients are given the opportunity to receive their full range. The hospital has its own clinical diagnostic laboratory, where you can do all the analyzes and examinations, as they say, on a turnkey basis. The organization also provides several IVF programs depending on the identified health problems.
For example, popular procedures using donor eggs, intrauterine insemination (abbreviated as IUI) and even surrogacy programs are available. A description of each program with a list of included services and costs can be found on the clinic's website. This fact indicates that the medical institution is open to meeting its clients and is ready to provide them with comprehensive information.

As for the qualifications of doctors, eight reproductologists are receiving appointments at the clinic. Information about each doctor can also be found on the website; in addition, there is the possibility of online consultations, which will be convenient for residents of remote areas. Patients can also make an appointment and ask a question to any specialist through the Internet resource.
The clinic uses high-tech innovative equipment, which increases the chances of success of the technique. As mentioned above, patients can find the cost of services on the website.But one more important fact is that services can be paid in installments. For such an expensive procedure, this is a definite plus. In addition, IVF can be done here not only for a fee, but also under the compulsory medical insurance policy.
Patient reviews are also published in the public domain. The advantage of these reviews is that they are addressed to a specific doctor. If patients have not yet decided on the choice of a specialist, then this service will help them with this. Statistics also speaks in favor of the Mother and Child clinic. The percentage of efficiency of the cycles is from 35 to 40%, which exceeds the world average.
It should be added that the medical complex has its own maternity hospital, and this allows you to observe the entire pregnancy, from the moment of conception to childbirth.
Address: st. Akademika Koroleva, 24, Sipailovo district
Phone: 8-800-700-700-1
Website: https://ufa.mamadeti.ru/
And again, a medical institution specializing in the reproductive health of men and women. One of the advantages of the center is that it is a network; in Ufa, they can be visited at three addresses in different districts. The medical center includes a polyclinic, a hospital, a department of assisted reproductive technologies and a department of fetal medicine, or prenatal medicine. As for the range of services and surveys provided, it is quite wide, and includes both traditional programs and specialized offers.
For example, for young families, a medical organization offers an IVF package "Young Family", which can be used by spouses under the age of 35. It includes services such as egg puncture, fertilization and embryo culture, as well as a set of medications to stimulate ovulation. In addition, the cost of such a package is quite affordable, but it allows providing high-quality treatment. In addition, IVF under compulsory medical insurance can be done in a medical organization.
The clinic employs six reproductive specialists, information about each doctor, his achievements and scientific and practical activities is posted on the center's website. All the necessary equipment is here, those who wish can go through a full range of procedures in one place.
The price list of the medical center gives patients full information about the services. As in the clinic "Mother and Child", services are packaged, each package is scheduled according to cost, you can make a comparison with the prices of other medical institutions.
On the site you can leave feedback on the work of doctors, tell your story. Patients can learn from the positive experiences of others.

Addresses: st. Kirov, 52; st. R. Sorge, 75; General Kusimov st., 15/1
Phone: 8-800-775-69-69
Website: www.eko-rb.ru
Another specialized infertility treatment facility. Before making a decision to carry out in vitro fertilization, future parents undergo a full clinical and diagnostic examination. The list of analyzes and procedures is presented on the website of the organization. Among them, in addition to the most necessary, you can find auxiliary hatching, when notches are made on the embryo's membrane, which help it to be released, and the MAP test, a method for determining antisperm immunity. The medical center includes a polyclinic, a hospital, an operating and embryological unit, as well as its own cryobank.
There are no questions about the qualifications of specialists either.The center accepts eight obstetricians-gynecologists and reproductologists, whose medical biographies can be viewed online. There is also no doubt about the first-class equipment, on which highly qualified employees of the MC "Semya" can provide such a wide range of services. Among them are cryopreservation of biological material and IVF donor programs.
Patients can also find the cost of services of this medical center on the website of the organization. Unlike the previous clinic, prices are indicated for each procedure separately. For some programs, you can find the total cost of the service (for example, using donor oocytes), but there is no price breakdown for each component. What else is worth paying attention to is not very flattering reviews about the cost of the technique in this clinic, some patients talk about them as being overpriced.

On the Internet portal of the medical center, there is a large number of reviews about the work of doctors. The plus is the fact that only authorized users can leave reviews. In the "Statistics" section on the same website there are more than one schedule with detailed information on the effectiveness of the procedures carried out in the center.
It should be added that potential parents wishing to try the IVF method can find a lot of useful information on the resource of the MC "Family", for example, the procedure for providing services on a quota, an overview of methods of treating infertility, and even a list of measures that contribute to a successful result.
Address: Prospect Oktyabrya, 73, building 1
Phone: (347) 246-03-67, 246-10-20 (multichannel)
Website: www.medufa.ru
This center is the only government agency in the ranking. The perinatal center is not specialized in the treatment of infertility; the range of its services includes pregnancy management and obstetric care for both healthy patients and women with various gynecological problems.
As for IVF, the medical institution provides a standard set of services, which includes the already familiar ICSI and PIXY, hatching, cryopreservation of biomaterial and embryos. The advantage of the perinatal center is a huge list of various clinical and diagnostic studies, as well as a large staff of various specialists, in addition to obstetricians and gynecologists, which women may need before, during and after pregnancy. As a matter of course, the center has the opportunity to do IVF on a quota.
The doctors working in the perinatal center have extensive experience and many years of experience in accompanying pregnancy. Specialists are carefully selected to meet government standards for healthcare.
However, there is very little information about the equipment used in the perinatal center. It is no secret that sometimes it is difficult to find advanced developments in government institutions, the equipment is outdated. Therefore, the question of equipment remains open and affects the position in the rating.
Despite this, on specialized forums you can find a lot of positive feedback from people who became parents thanks to the high-quality work of the doctors of the perinatal center. For the most part, these reviews are associated with specific specialists, and not with the medical institution itself. There is no clear statistics on the percentage of successful procedures, which also does not add points to this treatment center. <
Address: st. Aurora, 16
Phone: (347) 293-97-27
Website: http://rkpcufa.ru/

Summing up, it is worth recalling that the choice of a clinic for artificial insemination is a very important and responsible decision, on which not only the future of the child depends, but also the health of the mother. Therefore, when deciding where it is better to turn, you must first of all rely on statistics and positive feedback from other patients, and rely not on the medical institution itself, but on a specific specialist who has many successful IVF procedures behind him. The tips in this article will help you stay on course and make the right choice.